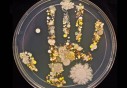

Traversée sur le Tariq Ibn Ziyad : L’ENTMV à la rescousse de la SNCM
Traversée sur le Tariq Ibn Ziyad : L’ENTMV à la rescousse de la SNCM
-
 Santé
17-05-2019 | 15:37
Santé
17-05-2019 | 15:37Ouargla: Lancement d’un large programme préventif contre les maladies épidémiques durant l’été
-
 Santé
17-05-2019 | 15:34
Santé
17-05-2019 | 15:34Hypertension artérielle: Nécessité de sensibiliser les jeunes à l'importance d'adopter un bon régime alimentaire (spécialiste)
-
 Santé
17-05-2019 | 15:12
Santé
17-05-2019 | 15:12Faire du vélo rend heureux
-
 Santé
17-05-2019 | 15:10
Santé
17-05-2019 | 15:108 bonnes raisons de se mettre au vélo !
-
Santé
17-05-2019 | 15:06
Santé
17-05-2019 | 15:06des photos pour montrer toutes les bactéries qui vivent sur nos mains
-
 Santé
17-05-2019 | 15:03
Santé
17-05-2019 | 15:03La malbouffe augmenterait le risque de cirrhose non alcoolique
-
 Santé
15-05-2019 | 15:01
Santé
15-05-2019 | 15:01les enfants de 6 ans ne sont pas tous égaux
-
 Santé
15-05-2019 | 14:56
Santé
15-05-2019 | 14:56Le chocolat noir protègerait notre cœur
-
 Santé
15-05-2019 | 14:54
Santé
15-05-2019 | 14:54Genou fragile : les bons traitements
Flux RSS DKNEWS-DZ.COM

LES FLASH ACTU
TOUTES LES NEWS
-
Césariennes plus risquées qu'un accouchement par voie basse ?
Les femmes de plus de 35 ans auraient plus de risques de faire une hémorragie suite à une césarienne.
-
Coronavirus - vaccin Poutine: ‘’la Russie a développé le premier vaccin’’
La Russie a développé le premier vaccin contre le nouveau coronavirus (Covid-19), a affirmé mardi le président russe lors d'une vidéo-conférence, assurant qu'il donnait une "immunité durable".
-
Coronavirus - vaccins OMS: ‘’plus de 100 milliards de dollars seront nécessaires pour garantir l'accès aux vaccins’’
Plus de 100 milliards de dollars seront nécessaires pour garantir l'accès de tous à des vaccins contre la Covid-19, a affirmé lundi le directeur général de l'Organisation mondiale de la santé (OMS), Tedros Adhanom Ghebreyesus.
-
Espagne - Coronavirus L'Espagne reconnaît ne pas contrôler "parfaitement" la contagion
Les autorités sanitaires espagnoles ont reconnu lundi qu'elles ne parvenaient pas à contrôler "parfaitement" la contagion du nouveau coronavirus alors que l'Espagne a enregistré en deux semaines..
-
Etats-Unis Plus de 97.000 enfants testés positifs au COVID-19 au cours de la deuxième quinzaine de juillet
L'Académie américaine de pédiatrie (American Academy of Pediatrics) et l'Association des hôpitaux d'enfants (Children's Hospital Association), ont indiqué que plus de 97.000 enfants américains..
-
Brésil 22.048 infections et 703 décès en 24 heures
Le Brésil a enregistré 22.048 nouveaux cas d'infection au nouveau coronavirus (Covid-19) ainsi que 703 décès durant els dernières 24 heures, a annoncé le ministère de la Santé.
-
Pandémie dans le monde Au moins 736.828 décès
La pandémie de coronavirus a engendré au moins 736.828 décès dans le monde depuis que le bureau de l'OMS en Chine a fait état de l'apparition de la maladie fin décembre, selon un nouveau bilan établi à partir de sources officielles hier.
-
Mise en quarantaine Boumerdes: mise en quarantaine de 274 ressortissants algériens rapatriés d’Arabie Saoudite
La Direction de la santé et de la population de Boumerdes a accueilli lundi 274 ressortissants algériens rapatriés d'Arabie Saoudite qui ont été placés en quarantaine à la résidence officielle..
L'EDITO
Le Président de la République, Abdelaziz Bouteflika, a reçu hier le Premier ministre français, Jean-Marc Ayrault, en visite officielle en Algérie. L'audience s'est déroulée en présence du Premier ministre, Abdelmalek Sellal. Lors de cette audience...
LIRE LA SUITEPHOTOS & VIDEOS
-
LE FORUM 14-04-2014 | 15:41Mr Abdelaziz Belkhadem au Forum de DK News 14/04/2014
CHRONIQUES
-
 Walid B
Walid B
Grâce à des efforts inlassablement consentis et à une efficacité fièrement retrouvée, la diplomatie algérienne, sous l’impulsion de celui qui fut son artisan principal, en l’occurrence le président de la République Abdelaziz Bouteflika, occupe aujour
-
 Boualem Branki
Boualem Branki
La loi de finances 2016 n’est pas austère. Contrairement à ce qui a été pronostiqué par ‘’les experts’’, le dernier Conseil des ministres, présidé par le Président Bouteflika, a adopté en réalité une loi de finances qui prend en compte autant le ress
-
 Walid B
Walid B
C'est dans le contexte d'un large mouvement de réformes sécuritaires et politiques, lancé en 2011, avec la levée de l'état d'urgence et la mise en chantier de plusieurs lois à portée politique, que ce processus sera couronné prochainement par le proj
-
 Boualem Branki
Boualem Branki
La solidité des institutions algériennes, la valorisation des acquis sociaux et leur développement, tels ont été les grands messages livrés hier lundi à Bechar par le ministre de l'Intérieur et des Collectivités locales Nouredine Bédoui.
-
 DK NEWS
DK NEWS
Le gouvernement ne semble pas connaître de répit en cette période estivale. Les ministres sont tous sur le terrain pour préparer la rentrée sociale qui interviendra début septembre prochain.
-
 Walid B
Walid B
Dans un contexte géopolitique régional et international marqué par des bouleversements de toutes sortes et des défis multiples, la consolidation du front interne s'impose comme unique voie pour faire face à toutes les menaces internes..
-
 Walid B
Walid B
Après le Sud, le premier ministre Abdelmalek Sellal met le cap sur l'Ouest du pays où il est attendu aujourd'hui dans les wilayas d'Oran et de Mascara pour une visite de travail et d'inspection.









 MAMI : Au cœur d’une usine algérienne de production de boissons gazeuses et de jus algériens
MAMI : Au cœur d’une usine algérienne de production de boissons gazeuses et de jus algériens  Laiterie Soumam : Les secrets d’une réussite
Laiterie Soumam : Les secrets d’une réussite  Lutte contre la drogue : Signature d’un accord entre le ministère des Affaires religieuses et l’ONLDT
Lutte contre la drogue : Signature d’un accord entre le ministère des Affaires religieuses et l’ONLDT 

